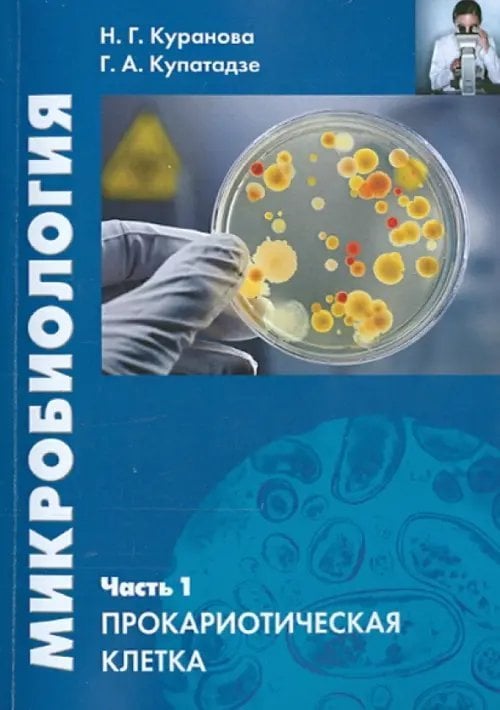
Микробиология. Часть 1. Прокариотическая клетка. Учебное пособие

Аннотация: Микробиология. Часть 1. Прокариотическая клетка. Учебное пособие
| Автор/составитель | Куранова Наталия Геннадиевна, Купатадзе Галина Александровна |
| Год выпуска | 2021 |
| ISBN | 978-5-00172-135-2, 978-5-7042-2459-4 |
| Производитель | Прометей |
| Издательство | Прометей |
| Количество томов | 1 |
| Количество страниц | 108 |
| Переплет | Мягкая обложка |
| Размеры | 200x140x7 мм |
| Цвет | Синий |
| Тип бумаги | офсетная (60-220 г/м2) |
| Формат | 60x90/16 (145x215 мм) |
| Стандарт | 10 |
| Вес | 136 |
| Язык | русский |
Пособие - первая часть комплекта по теоретическому блоку курса микробиологии, предназначенная для получения базовых знаний, а также для углубленного изучения материала при самоподготовке. Пособие включает в себя обзор прокариотической клетки: морфологии, строения поверхностных и внутренних структур, генома. Обсуждаются вопросы размножения и клеточного цикла. Особое внимание уделено сравнению клеток про- и эукариот и разнообразию клеток различных групп прокариот. Учебное пособие предназначено для студентов и бакалавров педагогических вузов, обучающихся по биологическим специальностям. 2-е издание, стереотипное.


 Google
Google